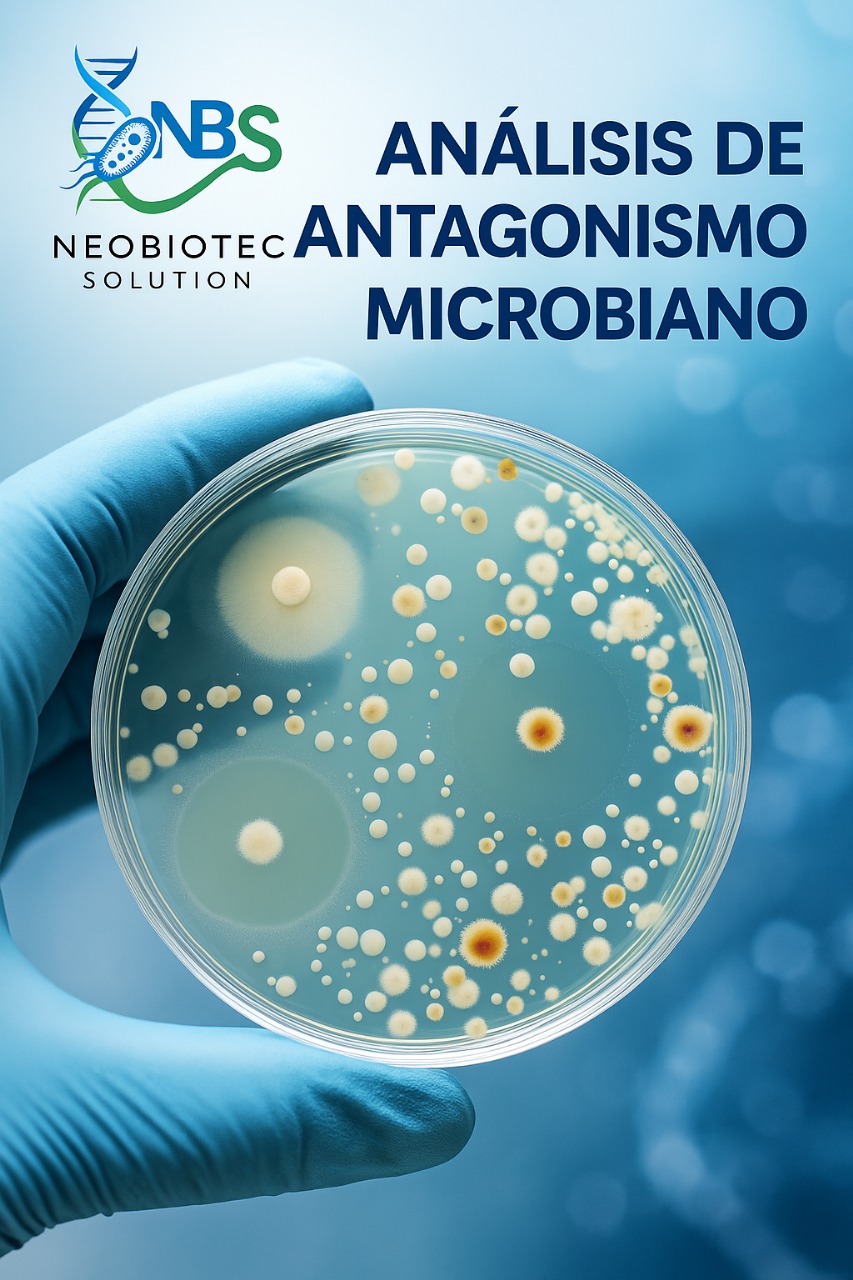
Análisis de antagonismo microbiano

Ciencia que genera confianza
Ensayos microbiológicos, análisis moleculares y consultoría científica con rigor científico y alto impacto
Servicios con tecnología de última generación a su disposición
Somos una empresa especializada en biotecnología y microbiología molecular, comprometida con la excelencia científica y la innovación. Ofrecemos soluciones integrales para la industria, academia y sector público con los más altos estándares de calidad.



Misión
Impulsar soluciones de biotecnología y microbiología con rigor científico y alto impacto, contribuyendo al desarrollo sostenible y la mejora de la calidad de vida.
Visión
Ser referente regional en I+D+i y soporte analítico para industria, academia y sector público, liderando la innovación en biotecnología molecular.
Tecnología Avanzada
Equipos de última generación para análisis precisos y confiables
Análisis Molecular
Técnicas moleculares avanzadas para identificación y caracterización
Rigor Científico
Metodologías validadas y estándares internacionales de calidad
Nuestro Equipo
Ciencia que genera confianza puesta en personas.

Mario David Cueva Távara
Biotecnología molecular y metagenómica
Doctoris Philosophiae en Ciencias e Ingeniería Biológicas – UNALM; M.Sc. en Biotecnología Molecular
Biólogo orientado a tecnologías ómicas en sectores ambiental y acuícola. Investigación en clonaje y estudio de proteínas virales; experiencia en metagenómica y espectrometría de masas MALDI-TOF/TOF.

Max Salvatierra Alor
Genética y biotecnología molecular
M.Sc. Biotecnología Molecular – Universidad Nacional de Tumbes
Biólogo Genetista Biotecnólogo (UNMSM). Experiencia en proyectos I+D+i para acuicultura y valorización de residuos, laboratorio de patología, control de calidad, docencia y bioinformática aplicada.

Carlos Condemarín Montealegre
Fisiología y biotecnología vegetal
Máster en Producción, Protección y Mejora Vegetal – Universidad de Córdoba (España)
Especialista en micropropagación y selección asistida por marcadores. Proyectos en microbiomas de agua/suelo/plantas bajo estrés y fitopatología; análisis NGS y bioinformática masiva.

Luis Aldo López Luna
Biotecnología aplicada y valorización de subproductos
Especialista en Biotecnología Molecular (I+D+i)
Gerente general e investigador (BIOTECOOP). Experto en control molecular de enfermedades en acuícola/pecuario/agrícola y producción de bioinsumos; nutrición experimental y KBBE.

Melitza Cornejo La Torre
Biotecnología minero-ambiental y ecotoxicología
Doctorado en Ingeniería y Ciencias Ambientales – UNALM (en curso)
Más de 12 años en I+D+i para minería e hidrocarburos: cierre y rehabilitación ambiental con microorganismos de ambientes extremos; liderazgo técnico-financiero de proyectos públicos y privados.

Miki Gonzales Uscamayta
Productos naturales y nanotecnología
Doctoris Philosophiae en Ciencias e Ingeniería Biológicas – UNALM; Magíster en Química – PUCP
Enfoque en moléculas bioactivas: aislamiento y evaluación antioxidante in vitro/in vivo; biosensores con levadura; péptidos antioxidantes; nanocelulosa en sensores.
Áreas de Laboratorio
Nuestros laboratorios especializados están equipados con tecnología de vanguardia para brindar servicios de análisis y investigación de la más alta calidad

Capacidades:
- Identificación molecular de microorganismos (16S rRNA, ITS, otros)
- Identificación molecular de especies (barcoding, genes específicos)
- Caracterización molecular de poblaciones microbianas por metagenómica (identificación y cuantificación relativa)
- Marcadores moleculares

Capacidades:
- Aislamiento y caracterización de cepas (bacterias, hongos)
- Determinación de pureza bacteriana y fúngica
- Recuento total de microorganismos (bacterias, hongos, levaduras)
- Viabilidad de esporas
- Cinética de crecimiento microbiano
- Recuento de microorganismos funcionales del suelo
- Aislamiento e identificación de patógenos en alimentos, suelos, compost, agua
- Bioensayos de sinergismo y antagonismo

Capacidades:
- Respiración microbiana en suelo
- Análisis proximal de alimentos y harinas
- Cuantificación de metales en agua, suelo y otras matrices
- Caracterización físico-química de suelos y agua
- Materia orgánica total, micro y macronutrientes
- Cuantificación de compuestos fenólicos totales
- Indicadores bioquímicos (OD, DBO, DQO, otros)

Capacidades:
- Experimentos de propagación vegetal y ensayos controlados en condiciones de laboratorio

Capacidades:
- Ensayos de toxicidad aguda y crónica en agua y sedimentos con peces, insectos, microalgas y otros organismos
Servicios y Productos
Ofrecemos una amplia gama de servicios especializados en biotecnología y microbiología molecular

Aislamiento e identificación de patógenos y otros microorganismos de interés
Aislamiento e identificación de patógenos y otros microorganismos relevantes para estudios específicos.

Análisis barcoding y metabarcoding de origen variado
Análisis molecular para identificar y clasificar organismos utilizando técnicas de barcoding y metabarcoding.
Análisis de antagonismo microbiano
Evaluación de las interacciones competitivas entre microorganismos.

Análisis de respiración microbiana en suelo
Medición de la actividad respiratoria microbiana en muestras de suelo.

Análisis proximal de alimentos
Determinación de la composición básica de los alimentos, incluyendo humedad, cenizas, proteínas, grasas y carbohidratos.

Cuantificación de macro y micronutrientes
Medición de la concentración de nutrientes esenciales en una muestra.

Cuantificación de metales totales
Medición de la cantidad total de metales presentes en una muestra.

Detección de Listeria monocytogenes
Identificación de la presencia de Listeria monocytogenes en una muestra.

Detección de Salmonella y Shiguella
Identificación de la presencia de Salmonella y Shiguella en una muestra.

Determinación de cinética de crecimiento
Análisis del crecimiento microbiano en función del tiempo.

Ensayos de inhibición o sinergismo bacteriano
Pruebas para determinar la inhibición o efectos sinérgicos entre diferentes cepas bacterianas.

Ensayos ecotoxicológicos
Pruebas para evaluar los efectos tóxicos de sustancias en organismos del ecosistema.
Investigaciones Realizadas
Nuestros proyectos de investigación contribuyen al avance del conocimiento científico y al desarrollo de soluciones innovadoras

Characterization and Evaluation of the Efficiency of Organic Amendments and Native Macrophytes for the Treatment of Acid Mine Drainage in Hualgayoc—A Case Study
The study evaluated organic amendments and native macrophytes for acid mine drainage (AMD) remediation in Hualgayoc, Peru. Sludge biochar (SLB) fully removed Zn, while corn stalk biochar (CSB) eliminated over 90% of Cu and Fe and showed the highest sorption capacity. Cattle manure compost (CMC) was most effective for As and Cd removal. Among plants, Carex pichinchensis removed ~97% Fe, and Myriophyllum aquaticum showed Cd affinity. Overall, organic amendments outperformed macrophytes, and combining both is recommended for improved AMD remediation.

Detección del virus de la tilapia del lago (TiLV) mediante semi-nested RT-PCR en tilapias cultivadas provenientes de dos regiones del Perú
This study investigated outbreaks of Tilapia Lake Virus (TiLV) causing over 60% mortality in two tilapia farms in Piura and San Martín, Peru. Liver and brain samples from 70 affected fish showing lethargy, appetite loss, and lesions were analyzed using semi-nested RT-PCR targeting segment 3 of the virus. Amplified products of 250 bp confirmed TiLV presence in both farms. Phylogenetic analysis revealed over 90% genetic identity with the Israeli reference strain (KU751816.1), indicating close relatedness among Peruvian isolates.

Efficient cloning of tilapia lake virus complementary DNAs using an in vivo strategy in baker's yeast
Cloning and protein expression in heterologous systems are very useful tools for the study of viral proteins. In this work, an in vivo cloning strategy was applied using the yeast Saccharomyces cerevisiae, as an efficient and low-cost method to clone several cDNAs from the tilapia lake virus (TiLV). Samples of infected tilapia Oreochromis niloticus tissues were taken and used to isolate their RNA and to obtain and clone the ten viral cDNAs in a shuttle plasmid. The cloning efficiencies range from 5 to 100% but for seven of the cDNAs the values were above 40%, demonstrating the high efficiency of the method.

Caracterización molecular de bacterias cultivables y no cultivables procedentes de pozas de lixiviación con cianuro
En el presente estudio, las comunidades bacterianas en muestras de suelo y agua, procedentes de pozas artesanales de lixiviación con cianuro, fueron caracterizadas por análisis dependientes e independientes de cultivo. Para la caracterización de la comunidad bacteriana cultivable, se emplearon técnicas clásicas de microbiología hasta la obtención de cepas puras, las cuales fueron identificadas a nivel molecular. Por otro lado, las comunidades bacterianas no cultivables fueron caracterizadas por secuenciación de próxima generación del gen ARNr 16S. La comunidad bacteriana cultivable estaba principalmente representada por los géneros Pseudomonas, Bacillus y Acinetobacter; mientras que las comunidades no cultivables, predominantes en muestras de suelo, fueron los filos Proteobacteria (12.91%), Firmicutes (11.32%), Actinobacteria (11.25%) y Bacteroidetes (10.16%). Por otro lado, en muestras de agua predominaron los filos Firmicutes (59.16%) y Actinobacteria (38.99%).
Preguntas Frecuentes
Encuentra respuestas a las preguntas más comunes sobre nuestros servicios
Contacto
Estamos aquí para ayudarte. Contáctanos para solicitar una cotización o resolver cualquier consulta
Confidencialidad: Toda la información proporcionada será tratada con estricta confidencialidad y utilizada únicamente para fines de cotización y comunicación comercial.
Horarios
Lunes a Viernes: 8:00 AM - 6:00 PM
Sábados: 8:00 AM - 12:00 PM
Domingos: Cerrado
